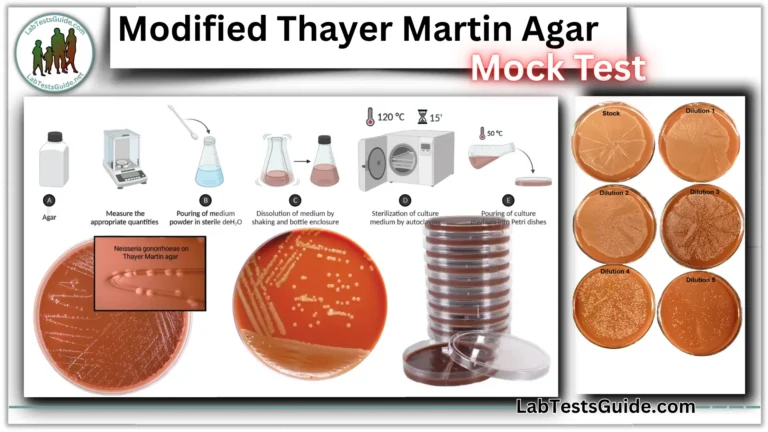
Modified Thayer Martin Agar MCQs Mock Test

Benedict’s Test: Principle, Composition, Preparation, Procedure & Result Interpretation
The Benedict’s test is a chemical test that can be used to test for the presence of reducing sugars in a given sample. Therefore, with this test, simple carbohydrates containing a free ketone or aldehyde functional group can be identified. The test is based on Benedict’s reagent (also known as Benedict’s solution), which is a complex mixture of sodium citrate, sodium carbonate, and copper (II) sulfate pentahydrate. When exposed to reducing sugars, the reactions undergone by Benedict’s reagent result in the formation of a brick-red precipitate, indicating a positive Benedict test result.

The Benedict test is used to detect simple carbohydrates. The Benedict test identifies reducing sugars (monosaccharides and some disaccharides) that have free ketone or aldehyde functional groups. Benedict’s solution can be used to detect the presence of glucose in urine.
Objectives of Benedict test:
- To detect the presence of reducing sugar in the sample solution
- To diagnose diabetes mellitus by detecting glucose in a urine sample
- To estimate the concentration of reducing sugar in the sample solution
- To differentiate and identify extracted carbohydrates
Principle of Benedict’s Test:
When a reducing sugar is heated in the presence of an alkali, it is converted to enodiol (which is a relatively strong reducing agent). Therefore, when reducing sugars are present in the analyte, the cupric ions (Cu2+) in Benedict’s reagent are reduced to cuprous ions (Cu+). These cuprous ions form copper(I) oxide with the reaction mixture and precipitate as a brick-red compound.

The sodium carbonate present in Benedict’s reagent increases the pH of the sample solution-reagent mixture. Under warm alkaline conditions, reducing sugars tautomerize to strong reducing agents, enediols. These enediols reduce the cupric ions (Cu2+) (present as copper sulfate (CuSO4)) in Benedict’s reagent to cuprous ions (Cu+). Copper particles are present as insoluble copper(I) oxide or red cuprous oxide (Cu2O). These red copper oxides precipitate.
Reaction:
The concentration of reducing sugar in the sample differs from the intensity and shade of the color of the reaction mixture. This color tone can be used to estimate the concentration of reducing sugar in the sample. The color can vary from greenish to yellow, orange-red, or brick red. As the concentration of reducing sugar increases, the color gradually changes from greenish to yellowish, orange, or brick red.
Preparation of Benedictβs Reagent:
Preparation of Benedict’s Reagent (for 500 mL)
| Component | Amount | Notes |
|---|---|---|
| Copper(II) sulphate, 5-hydrate | 8.6 g | Use analytical grade |
| Sodium carbonate, anhydrous | 50.0 g | |
| Tri-sodium citrate | 86.4 g | |
| Distilled water | To 500 mL | Add water to make final volume |
Instructions:
- Dissolve Copper(II) sulphate, Sodium carbonate, and Tri-sodium citrate in distilled water separately.
- Combine the solutions and dilute to 500 mL with distilled water.
Requirements for Benedict’s Test:
- Unknown carbohydrate sample solution (or urine sample)
- Test tubes and test tube racks
- Pipette
- Bunsen burner
- Benedict’s reagent
Procedure of Benedict’s Test:

- Take three or more heat-resistant glass tubes and label them as follows:
- POS β Positive control
- NEG β Negative control
- Urine Sample β Patients’ tests
- Dispense 2.5 ml of Benedictβs reagent into each tube.
- Use a 2.5 ml plastic syringe or graduated plastic bulb pipette to dispense the reagent (calibrated pipette is not necessary).
- Add the following to each tube:
- POS (Positive control): 0.2 ml glucose control solution
- NEG (Negative control): 0.2 ml distilled or boiled filtered water
- Urine Sample. (Patient’s tests): 0.2 ml fresh patientβs urine
- Mix the contents of each tube.
- Place the tubes in a heat-block set at 100Β°C or a container of boiling water for exactly 5 minutes.
- Remove the tubes after heating and examine the solution in each tube for precipitate formation and any color change.

Benedict’s Test Results Interpretation
Any color change from blue to green, yellow, orange or red within 3 minutes indicates a positive Benedict test, i.e. the presence of reducing sugar in the sample.
For a semi-quantitative assessment, the concentration of reducing sugars can be estimated based on the color tone developed as follows:
| Appearance of Solution Color | Sugar Concentration |
|---|---|
| Blue, clear or cloudy | 0.0 g% (Nil) |
| Green, no precipitate | < 0.5 g% (Trace) |
| Green, with precipitate | 0.5 – 1.0 g% (+) |
| Brown and cloudy | 1.0 – 1.5 g% (++) |
| Orange and cloudy | 1.5 – 2.0 g% (+++) |
| Red and cloudy | > 2.0 g% (++++) |

Factors affecting the Benedict test:
- False positive reactions can also occur if certain drugs are present, e.g., salicylates, penicillin, streptomycin, isoniazid, and p-aminosalicylic acid.
- In concentrated urine, chemicals that can reduce the Benedict reaction include creatinine, urate, and ascorbic acid (the reduction is slight).
References:
- Benedictβs Test- Principle, Procedure, Steps, Results, Uses (Microbe Notes) – (Accessed on Sep 17, 2024)
- Benedictβs Test β Reagent Preparation, Principle, Procedure, Reaction (byjus.com) – (Accessed on Sep 17, 2024)
- Benedicts Test β Principle, Procedure, Result and Limitation (vedantu.com) – (Accessed on Sep 17, 2024)
- Benedictβs Test- Principle, Preparation, Procedure and Result Interpretation (microbiologyinfo.com) – (Accessed on Sep 17, 2024)
- Benedictβs test: Definition, Principle, Uses, and Reagent (chemistrylearner.com) – (Accessed on Sep 17, 2024)
- BBC Bitesize- Chemistry- Carbohydrates.
- University of Manitoba- The Molecules of Life: Biochemistry- Carbohydrates.
- Northern Kentucky University- Benedictβs Reagent: A Test for Reducing Sugars.
- KNUST Open Educational Resources, Benedictβs Test β Qualitative Test in Carbohydrates.
- Mark Rotheryβs Biology Web Site- Biochemical Tests.
- All Medical Stuff- Benedictβs test for reducing sugar.
- Hendrix College- Benedicts Test for Glucose.
- Info Please- Benedictβs solution.
- Mystrica- Benedictβs Test.
- Amrita Virtual Lab Collaborative Platform- Qualitative Analysis of Carbohydrates.
- Wikipedia.
- Robert D. Simoni; Robert L. Hill & Martha Vaughan (2002). βBenedictβs Solution, a Reagent for Measuring Reducing Sugars: the Clinical Chemistry of Stanley R. Benedictβ. J. Biol. Chem. 277 (16): 10β11. https://doi.org/10.1016%2FS0021-9258%2819%2961050-1